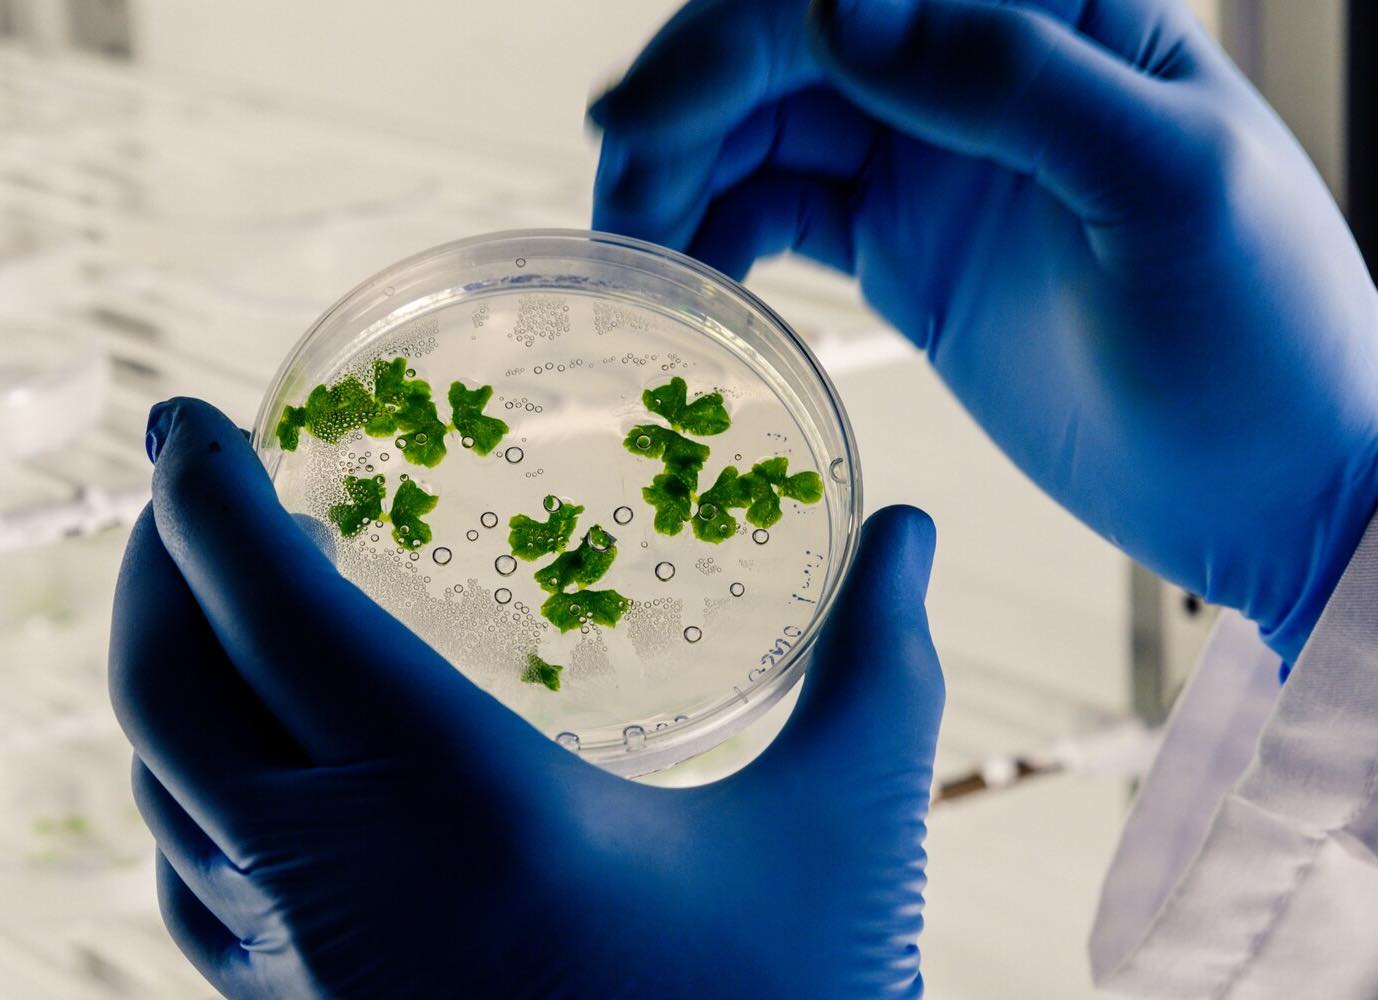

Caso Campobasso | emergono nuovi dettagli intossicazione alimentare sempre più dubbia
Nuovi dettagli emergono nel caso di Campobasso, riguardanti l’intossicazione alimentare sospetta che ha coinvolto Antonella Di Ielsi e sua figlia Sara Di Vita. Le due persone sono decedute all’ospedale Cardarelli dopo un improvviso collasso clinico. La vicenda solleva ancora dubbi e richiama l’attenzione sulle circostanze che hanno portato a questa tragica morte.
Emergono nuovi dettagli sul tragico caso di Antonella Di Ielsi e della figlia Sara Di Vita, decedute all’ospedale Cardarelli di Campobasso dopo un improvviso e drammatico collasso clinico. Le prime ipotesi di una classica. L'articolo proviene da Cibosia. 🔗 Leggi su Cibosia.it
© Cibosia.it - Caso Campobasso: emergono nuovi dettagli, intossicazione alimentare sempre più dubbia
Leggi anche: Madre e figlia morte per intossicazione alimentare a Campobasso: cinque indagati e nuovi sequestri
Leggi anche: Campobasso: muore a 16 anni, sospetta intossicazione alimentare
Tragedia a Campobasso: madre e figlia morte intossicate. 5 medici indagati; Mamma e figlia morte per intossicazione, svolta nel caso: perché cinque medici sono indagati.
Tragedia a Campobasso: madre e figlia morte intossicate. 5 medici indagati - Tragedia a Campobasso, madre e figlia morte intossicate: sotto indagine il sistema sanitario locale, 5 medici indagati ... mam-e.it
Radio1 Rai. . #Campobasso Il caso della morte di madre e figlia per una probabile #intossicazione alimentare. Indagati i 5 sanitari che per due volte le avevano dimesse dal Pronto soccorso. Intanto il marito della donna e padre della minore è ricoverato a Ro - facebook.com facebook
#Campobasso Il caso della morte di madre e figlia per una probabile #intossicazione alimentare. Indagati i 5 sanitari che per due volte le avevano dimesse dal Pronto soccorso. Intanto il marito della donna e padre della minore è ricoverato a Roma Eleonora F x.com
Sono disponibili ulteriori notizie e video informativi attraverso la ricerca dedicata.